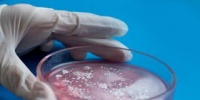
Микробы против пластика: как природа и наука объединяются для спасения планеты

Ученые из США создали сверхпрочные материалы из искусственной лунной пыли
Дом на Луне становится реальностью: ученые научились «плавить» лунную пыль

Peterburg2.ru
Исследователи из Огайо нашли способ печатать детали из лунного грунта. Новая технология может изменить метод к строительству на Луне. Эксперименты открывают неожиданные перспективы для Земли. Ученые продолжают тестировать возможности метода.
Планы по созданию постоянных баз на Луне обсуждаются уже не одно десятилетие, но только сейчас появляются реальные технологии, способные приблизить этот момент. Американские инженеры из Университета штата Огайо разработали уникальный способ производства строительных элементов из искусственного аналога лунного грунта. Их метод основан на 3D-печати с использованием мощного лазера, который плавит слои материала и формирует прочные детали. Такой метод может стать ключом к строительству автономных поселений на спутнике Земли.
Главная задача - научиться использовать то, что уже есть на Луне, ведь доставка грузов с Земли обходится слишком дорого. Поэтому ученые сосредоточились на технологии, позволяющей создавать необходимые конструкции прямо на месте, используя местные ресурсы. В лаборатории они применили синтетический реголит, максимально приближенный по составу к настоящей лунной пыли. С помощью лазера материал расплавлялся и наносился слоями на разные подложки. В результате удалось получить образцы, выдерживающие экстремальные температуры и механические нагрузки.
Особое акцент команда уделила подбору основ для печати. Оказалось, что металлические и стеклянные подложки не обеспечивают нужной прочности соединения. Зато керамика на основе алюмосиликата показала отличные результаты: детали прочно сцеплялись с поверхностью и сохраняли форму даже при резких перепадах температур. Исследователи экспериментировали с разными параметрами печати - изменяли мощность лазера, скорость нанесения слоев и состав среды. Каждый из этих факторов влиял на итоговые свойства материала.
По информации Peterburg2, ученые отмечают, что условия на Луне сложно воспроизвести в земных лабораториях. Вакуум, агрессивная пыль и постоянные температурные скачки требуют особого подхода к проектированию оборудования. Поэтому разработчики стремятся сделать свои системы максимально универсальными и адаптивными. Чем меньше зависимость от поставок с Земли, тем выше шансы на успех долгосрочных миссий.
Интересно, что полученные результаты могут быть полезны не только для освоения космоса. Если удастся наладить производство из местных материалов в условиях дефицита ресурсов, это откроет новые возможности и для земной промышленности. Сокращение логистических цепочек и переход к локальному производству - актуальная задача для многих отраслей. Ученые уже рассматривают варианты использования солнечной энергии вместо электричества для питания лазерных установок, что сделает процесс еще более автономным.
Впрочем, до реального строительства на Луне еще далеко. Необходимо провести дополнительные испытания, чтобы понять, как материалы поведут себя в настоящих лунных условиях. Тем не менее, сама идея использования реголита для создания инфраструктуры выглядит крайне перспективно. Это не только экономит ресурсы, но и позволяет быстрее реагировать на любые непредвиденные ситуации.
Команда из Огайо уверена: чем больше информации удастся собрать о поведении материалов в разных средах, тем шире будет спектр их применения. В будущем подобные технологии могут стать стандартом не только для космических миссий, но и для решения земных проблем устойчивого развития. Пока же ученые продолжают эксперименты, открывая новые горизонты для инженерии и науки.
 Ученые нашли способ выращивать овощи на Луне и Марсе с помощью отходов
Исследователи предлагают необычное решение для будущих колоний. Эксперименты удивляют даже скептиков. Как изменится жизнь на других планетах - читайте в материале....
Ученые нашли способ выращивать овощи на Луне и Марсе с помощью отходов
Исследователи предлагают необычное решение для будущих колоний. Эксперименты удивляют даже скептиков. Как изменится жизнь на других планетах - читайте в материале....  Ученые впервые напечатали 3D-объект внутри живой клетки человека
В лаборатории напечатали микроскопический объект прямо внутри клетки. Эксперимент удивил даже скептиков. Открытие может изменить метод к биоинженерии. Подробности - в нашем материале....
Ученые впервые напечатали 3D-объект внутри живой клетки человека
В лаборатории напечатали микроскопический объект прямо внутри клетки. Эксперимент удивил даже скептиков. Открытие может изменить метод к биоинженерии. Подробности - в нашем материале.... Микробы против пластика: как природа и наука объединяются для спасения планеты
Ученые открывают неожиданные возможности микробов. Пластик становится их пищей. Новые технологии меняют метод к переработке. Мир стоит на пороге экологических перемен....
Микробы против пластика: как природа и наука объединяются для спасения планеты
Ученые открывают неожиданные возможности микробов. Пластик становится их пищей. Новые технологии меняют метод к переработке. Мир стоит на пороге экологических перемен....  Ученые раскрыли роль кислорода в появлении сложных форм жизни на Земле
Исследователи пересмотрели взгляды на эволюцию жизни. Новые данные удивили научное сообщество. В центре внимания - загадочные археи и их энергетические возможности....
Ученые раскрыли роль кислорода в появлении сложных форм жизни на Земле
Исследователи пересмотрели взгляды на эволюцию жизни. Новые данные удивили научное сообщество. В центре внимания - загадочные археи и их энергетические возможности.... .png) Время в кристалле: ученые создали материю с уникальным поведением
Исследователи добились создания двумерного кристалла времени. Материя ведет себя необычно и не подчиняется привычным законам. Это открывает новые горизонты для квантовых разработок....
Время в кристалле: ученые создали материю с уникальным поведением
Исследователи добились создания двумерного кристалла времени. Материя ведет себя необычно и не подчиняется привычным законам. Это открывает новые горизонты для квантовых разработок....  Могут ли пчелы подсказать нам способ общения с внеземным разумом
Ученые изучают, как пчелы решают задачи. Их навыки могут помочь понять универсальный язык. ...
Могут ли пчелы подсказать нам способ общения с внеземным разумом
Ученые изучают, как пчелы решают задачи. Их навыки могут помочь понять универсальный язык. ... .jpg) Российский искусственный интеллект научился находить мусор в арктических морях
Ученые из России внедрили новую ИИ-систему для мониторинга морей. Технология превосходит зарубежные аналоги по точности. Эксперты обсуждают влияние мусора на экосистему Арктики. Впереди - испытания в суровых условиях....
Российский искусственный интеллект научился находить мусор в арктических морях
Ученые из России внедрили новую ИИ-систему для мониторинга морей. Технология превосходит зарубежные аналоги по точности. Эксперты обсуждают влияние мусора на экосистему Арктики. Впереди - испытания в суровых условиях....  Циклы орбиты Земли помогают находить новые залежи сланцевой нефти
Ученые нашли необычную связь между движением Земли и формированием нефти. Новые методы поиска ресурсов удивляют даже опытных специалистов. Открытие может изменить подход к разведке полезных ископаемых....
Циклы орбиты Земли помогают находить новые залежи сланцевой нефти
Ученые нашли необычную связь между движением Земли и формированием нефти. Новые методы поиска ресурсов удивляют даже опытных специалистов. Открытие может изменить подход к разведке полезных ископаемых....  Ученые синтезировали противораковое вещество из грибов и нашли золотую акулу
Свежие открытия в науке удивляют и ставят вопросы. Новые данные о ДНК животных в крови комаров. Уникальный фильтр для микропластика вдохновлен рыбами. Неожиданные находки в мире природы и медицины....
Ученые синтезировали противораковое вещество из грибов и нашли золотую акулу
Свежие открытия в науке удивляют и ставят вопросы. Новые данные о ДНК животных в крови комаров. Уникальный фильтр для микропластика вдохновлен рыбами. Неожиданные находки в мире природы и медицины.... Рекомендовано Петербургом 2
|
Главные события весны в Петербурге: «Пикник», гала-концерт в честь Майи Плесецкой и 45-летие Ленинградского рок-клуба
В Эрмитаже представили иммерсивную выставку о судьбе античной статуи
Путешествия по Кольскому полуострову: маршруты, природа и особенности региона
Как выбрать идеальные места в театре и не пожалеть
Что делать, если в квартире потекла крыша: инструкция для петербуржцев
Топ-события Петербурга на этой неделе: Artik и Asti, Алексей Чумаков и Шура














